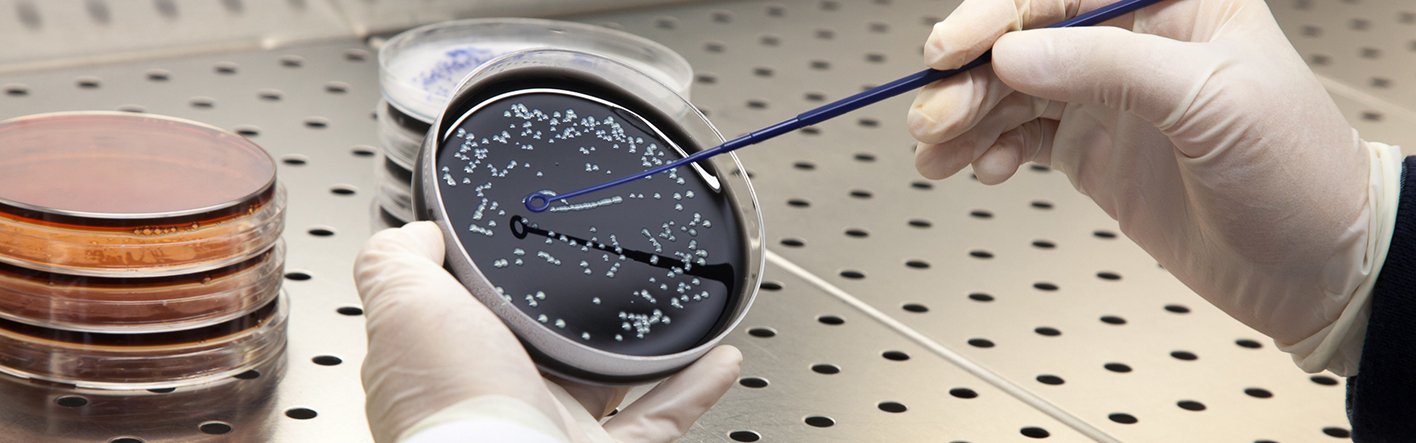
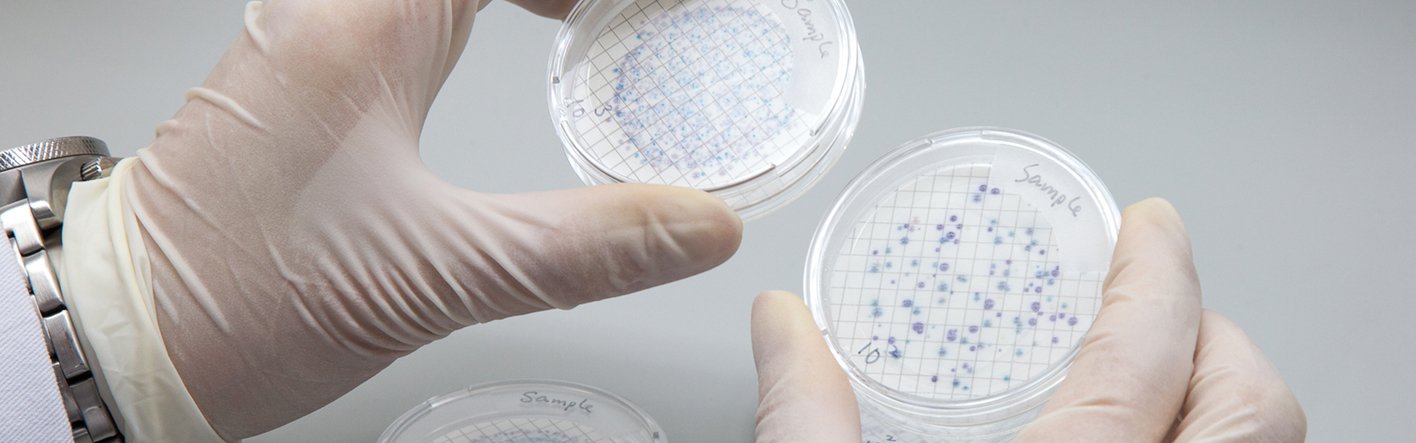

A new testing service for ETL, our Microbiology division offers a wide range of microbiological analysis of environmental water samples as well as antimicrobial tests for consumable products, such as Heterotrophic plate count, Total coliforms, Faceal coliforms, E. coli, Legionella, and the presence of amoeba and pathogens.
Our experienced technical staff design testing protocols fit for each client's product specification, and offer diverse services such as swab test analysis, antimicrobial efficacy tests in textiles and plastics, and disinfection products and water filters, amongst others.
For further information or to receive a quote, please contact the Microbiology team.
-
Legionella in cooling tower water and drinking water, including Legionella Pneumophila
-
Heterotrophic Plate Count (Total Bacterial Count) in Water Samples
-
Total Coliforms in Drinking Water & Marine Water
-
E. coli in Drinking Water & Marine Water
-
Faecal Coliform in Drinking Water & Marine Water
-
Presence of Amoeba
-
Staphylococcus aureus in Water Samples
-
Pseudomonas aeruginosa in Water Samples
-
Vibrio cholera in Water Samples
-
Enterococci in Water & Wastewater Samples
-
Clostridium perfringens in Water Samples
-
Antimicrobial Effectiveness Test on Water Filter System
-
Antibacterial & Antifungal Activity on Textile Materials
-
Antibacterial Activity on Plastics Surfaces
-
Antibacterial & Antifungal Removal Test on Disinfection Products & Sanitizers
-
Swab Test on Surfaces to Determine the Level of Hygiene
-
Hygienic Standard for Disposable Sanitory Products, including Face Mask
-
Microbiological Examination of Cosmetics
-
Total Bacterial Count in Indoor Environment
-
Total Fungal Count in Indoor Environment
Job Reference
Date: July 2024 to present
Division: Microbiology
Project: Provision of Sampling and Laboratory Analysis Services for Victoria Harbour Water Quality Surrey
Client: Environmental Protection Department
Date: August 2024 to present
Division: Microbiology
Project: Provision of Bacteria Analysis in Seawater to Fish Marketing Organization
Client: Fish Marketing Organization
Date: January 2025 to present
Division: Microbiology
Project: Provision of Water Sampling Testing Services in Campus of EdUHK (2025)
Client: The Education University of Hong Kong
Date: January 2025 to present
Division: Microbiology
Project: Antimicrobial Effectiveness Test
Client: Nano & Advanced Materials Institute Ltd.